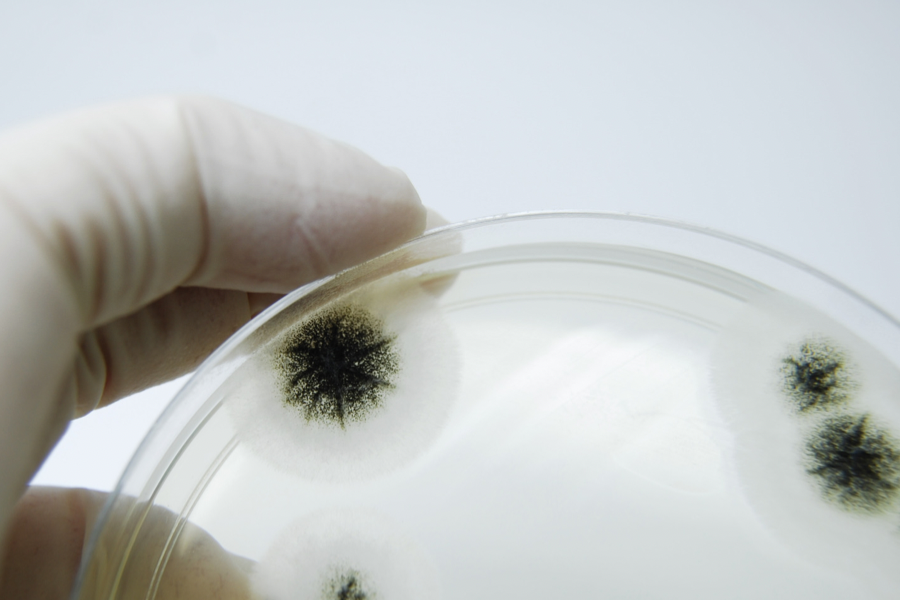

Introduction

Citric acid, a natural component found in citrus fruits, is more than just a sour flavor enhancer. This alpha-hydroxy acid (AHA) has carved a niche for itself in the beauty industry, thanks to its multifaceted benefits for the skin. Let’s delve into the world of citric acid and understand its role in beauty products.
What is Citric Acid?

Citric acid is an organic compound with the chemical formula C6H8O7. It’s a weak acid that naturally occurs in citrus fruits such as lemons, limes, and oranges. In the realm of skincare, citric acid is celebrated for its antioxidant properties and its ability to promote skin renewal.
The Origin Story

The discovery of citric acid dates back to 1784 when it was first isolated from lemon juice by the Swedish chemist Carl Wilhelm Scheele. Today, citric acid is manufactured on a large scale through the fermentation of cane sugar or molasses in the presence of the fungus Aspergillus Niger.
The Production Process
The industrial production of citric acid involves a fermentation process where the fungi Aspergillus niger metabolizes sugars to produce citric acid. This method is preferred over extraction from citrus fruits due to its cost-effectiveness and the ability to meet high demands.
Impact on Our Skin

When used in skincare, citric acid acts as an exfoliant. It helps in the shedding of dead skin cells, promoting new cell growth, and can lead to a brighter, more even skin tone. Studies have shown that using a 20% citric acid solution for three months can thicken the skin, reduce sun damage, and increase skin hydration.
Potential Side Effects

While citric acid is generally safe for use in skincare, it can increase skin sensitivity to UVB radiation, making sun protection even more crucial. It’s also been found to be more sensitizing than other AHAs, so it’s often blended with other ingredients to minimize irritation.
Environmental Considerations

Citric acid is generally considered environmentally friendly due to its natural origin and biodegradability. Derived from citrus fruits or through fermentation of sugars, citric acid is a sustainable alternative to harsher chemical exfoliants. Its production has a relatively low environmental impact, especially when compared to synthetic ingredients. Additionally, citric acid is used in eco-friendly processes, such as the extraction of candelilla wax, which is safer for the environment. However, it’s important to consider the overall lifecycle of beauty products containing citric acid, including packaging and transportation, to fully assess their environmental footprint.
Products Containing Citric Acid

Citric acid is prevalent in many beauty products, from cleansers and toners to serums and moisturizers. Some of the most prevalent and well-known products include:
- Bioderma Sebium Global Intensive Purifying Care – This product is designed to help purify and balance oily skin.
- Erno Laszlo AHA Resurfacing Sleep Serum – A luxurious serum that works overnight to resurface and rejuvenate the skin.
- Paula’s Choice Skin Perfecting 8% AHA Gel Exfoliant – This gel exfoliant helps to smooth and brighten the skin by promoting cell turnover.
- The Ordinary Glycolic Acid 7% Toning Solution – While primarily featuring glycolic acid, it also contains citric acid to enhance its exfoliating properties.
These products leverage citric acid’s exfoliating and pH-balancing benefits to improve skin texture and appearance.
The Verdict

Citric acid is a multifaceted ingredient that provides numerous skin benefits, such as antioxidant protection, exfoliation, skin renewal, pH balance, and a brightening effect. However, it is crucial to use it judiciously due to its potential side effects and environmental impact. When you find citric acid in your skincare products, it’s reassuring to know it’s beneficial for your skin, but it’s important to combine it with sunscreen to guard against heightened UV sensitivity. Ideally, seek products that include both citric acid and SPF. Additionally, opt for products committed to sustainability.
Conclusion

In conclusion, citric acid is not only an incredibly valuable ingredient in the beauty industry but also a powerful ally in maintaining healthy, glowing skin. With its amazing range of benefits, this natural compound continues to be a staple in numerous skincare formulations, delivering mother nature’s own skin-loving goodness right to our doorsteps. From exfoliating dead skin cells to reducing fine lines and wrinkles, citric acid truly works wonders for our complexion. Its multifunctional nature also makes it an undisputed champion of natural skincare, providing a host of benefits that help keep our skin looking young and radiant. So, if you’re looking to invest in a natural and effective skincare solution, look no further than citric acid – the ultimate skin superfood!


